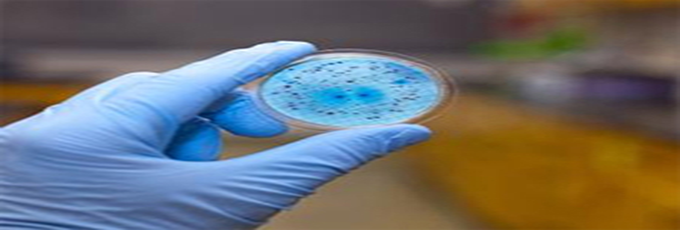
带你了解五大抗菌塑料的制备方法工艺

-

-












-
立即申请
-

2017-02-16 10:21:19

2017-02-15 14:17:16

2017-02-13 14:30:47

2017-02-07 14:14:08
2017-02-07 10:59:34

2017-02-06 09:47:09

2017-01-20 10:16:36

2017-01-20 10:09:14

2017-01-19 09:55:35

2017-01-19 09:50:46












关注高分子微信公众号